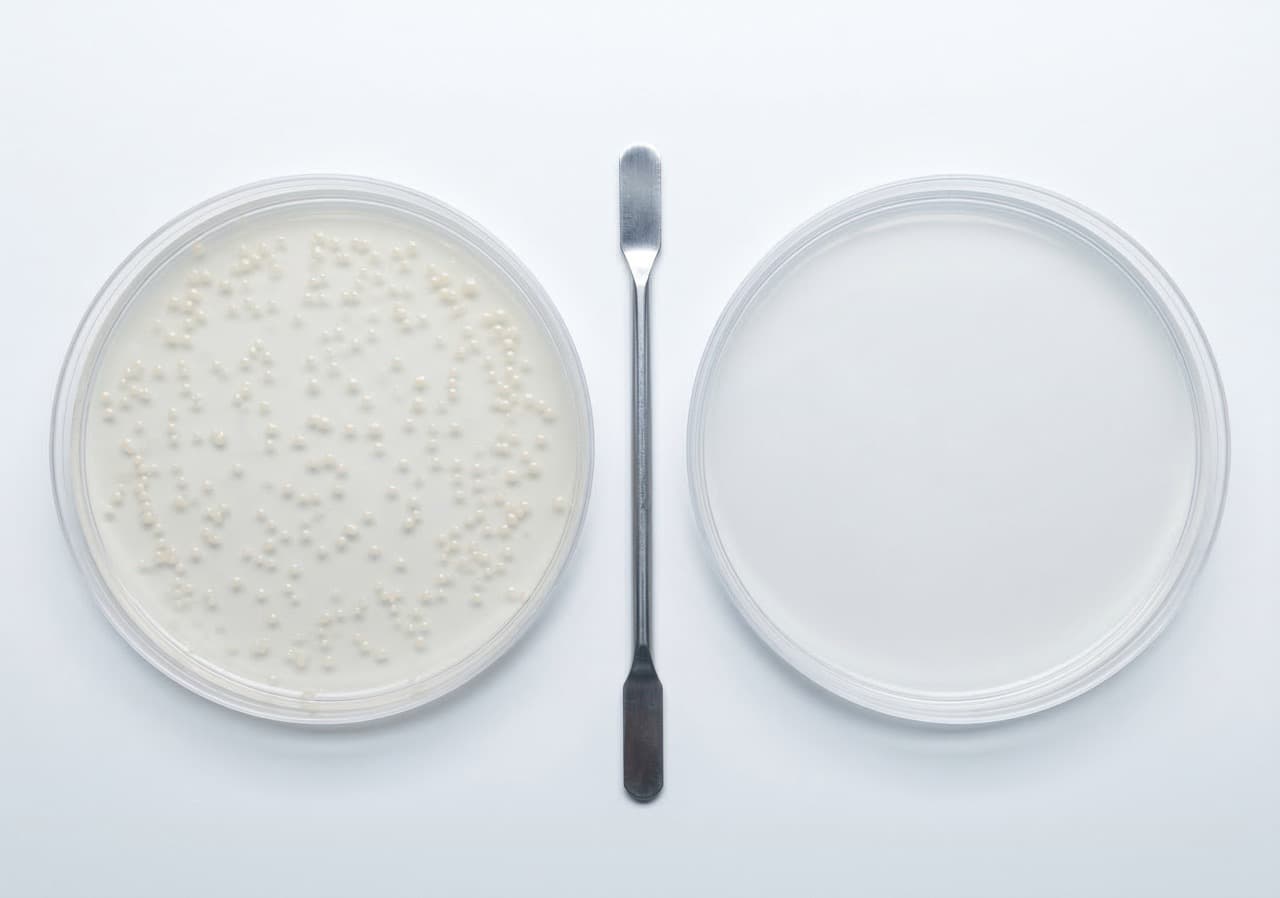
Two petri dishes side by side — bacterial colony growth visible in the composted litter sample (left) versus zero growth in the subcritically-treated sample (right) — illustrating the greater than 99.7% antibiotic residue destruction rate subcritical water hydrolysis achieves at 200°C, which conventional composting at 55–70°C cannot match.

Article Series
The true all-in cost of poultry litter disposal for a UK broiler or layer operation in an NVZ is £55–£85 per tonne — not the £20–£40 haulage figure on the invoice. The gap is made up of synthetic nitrogen you repurchase to replace the NPK you just exported, NVZ compliance overhead, and AD gate surcharges. On-site subcritical water hydrolysis eliminates the disposal cost and converts litter into a liquid fertiliser concentrate, with payback typically achieved in 18–28 months for operations hauling 600+ tonnes off-farm annually.

UK poultry farms generating litter volumes above their on-farm spreading capacity are carrying a disposal burden that most farm accounts don't calculate correctly — because the true cost is not the haulage invoice. It's the haulage invoice plus the synthetic nitrogen you're buying back to replace the NPK you just exported. Understanding that full-cost picture is the starting point of the UK Farm Waste Disposal Costs: £35–£180/t Guide, and this article applies that framework specifically to broiler and layer operations where NVZ nitrogen loading limits and AD facility rejection are compounding the disposal problem into a three-line cost exposure.
What Is the True Cost of Poultry Litter Disposal in the UK — Including NVZ and Fertiliser Replacement?
The real all-in cost of poultry litter disposal for a UK broiler or layer operation sitting in a Nitrate Vulnerable Zone is typically £55–£85 per tonne — not the £20–£40 haulage figure that appears on the contract.
- Haulage off-farm: £20–£40/tonne depending on haulier, distance, and litter moisture content
- NVZ compliance overhead: £5–£12/tonne in additional management and monitoring costs where spreading is already at the nitrogen loading threshold
- Synthetic nitrogen replacement allocated back to litter: £18–£35/tonne, based on the NPK value exported in the litter at current DAP and urea prices of £350–£500/tonne
- AD facility gate premium or rejection cost: £0–£15/tonne for operations routing to anaerobic digestion, where high-ammonia poultry litter is either rejected outright or charged a pre-treatment surcharge
This applies when your farm sits within a designated NVZ and generates litter tonnage that exceeds your holding's nitrogen loading allowance — it does NOT apply if you have sufficient spreading land to use all litter output within NVZ thresholds and are not repurchasing synthetic nitrogen at the farm gate.
Scenario: A 100,000-bird broiler unit generating 800 tonnes of litter per year, 60% of which must be hauled off-farm due to NVZ loading limits. At £40 haulage plus £25 in nitrogen replacement cost, that 480-tonne off-farm volume is costing £31,200 per year — before any AD rejection surcharges are added.

All-in cost breakdown per tonne (UK broiler, NVZ, 2024–25)
| Cost line | £/tonne |
|---|---|
| Haulage off-farm | £20–£40 |
| NVZ compliance overhead | £5–£12 |
| Synthetic N replacement | £18–£35 |
| AD gate surcharge (if applicable) | £0–£15 |
| True all-in total | £55–£85 |
| PHANTOM on-site (net after fertiliser) | −£16 to −£25 |
Why Are AD Facilities Rejecting Poultry Litter — and What Does That Gate Fee Actually Cost?

Anaerobic digestion facilities reject or penalise high-ammonia poultry litter because the ammonia concentration inhibits the methanogenic bacteria that generate biogas, reducing plant efficiency and increasing their own operating costs. Rejection is not random — it is a structural response to litter from intensive poultry operations.
- Typical ammonia threshold for AD acceptance: 3–5 g/L ammonia-nitrogen in the feedstock
- Broiler litter ammonia content: frequently 6–12 g/L — well above the acceptance threshold without dilution or pre-treatment
- Gate fee penalty for high-ammonia loads: £8–£15/tonne surcharge where the facility accepts but must blend with lower-ammonia feedstocks
- Outright rejection rate: estimated 30–40% of first-time poultry litter enquiries to UK AD operators, based on reported experience from the NFU's waste working group
This applies to operations routing dry litter or partially composted litter to a third-party AD facility — it does NOT apply to farms using a dedicated on-farm slurry digester or to operations whose litter has been mechanically dried to below 40% moisture content before transport.
Scenario: A 50,000-bird layer operation in the East of England routes 200 tonnes of litter to an AD facility and receives a £12/tonne surcharge plus a request to pre-treat before the next delivery. That adds £2,400 to the disposal invoice and introduces an operational dependency on a facility that may reject the next load without notice.
Does Spreading Poultry Litter on NVZ Land Below the Threshold Actually Reduce Your Cost — Or Does It Create a Different Compliance Risk?

Spreading within NVZ limits does reduce direct disposal cost — but only if the nitrogen loading calculation is being done correctly for poultry litter, which has a higher nitrogen content per tonne than cattle slurry or pig manure and is frequently miscalculated against the 170 kg N/ha limit.
- Nitrogen content of broiler litter: typically 28–38 kg N/tonne (dry weight basis) — significantly higher than the 5–8 kg N/tonne of diluted cattle slurry
- The 170 kg N/ha NVZ limit equates to approximately 4.5–6 tonnes of poultry litter per hectare per year
- Under-reporting nitrogen loading from poultry litter is one of the top compliance triggers in EA farm inspections in designated NVZ areas
- Penalty exposure for spreading above the NVZ limit: formal warning, enforcement notice, and potential prosecution — fines up to £20,000 for serious or repeat breaches under the Nitrates (England) Regulations 2015
This applies when you are relying on litter spreading as your primary disposal route — it does NOT apply if your litter is being hauled off-farm entirely, though the underlying nitrogen content calculation still determines the value of the fertiliser you are exporting.
Scenario: An estate manager with 800 ha of arable land and a 120,000-bird broiler tenancy calculates the spreading allowance at 5 tonnes/ha across 200 ha of available land — 1,000 tonnes — which appears to cover the full litter output. The calculation fails to account for the second crop nitrogen application in the same calendar year, pushing the actual field loading 22% above the NVZ limit across three fields.
NVZ Compliance Risk Checklist
Tick every statement that applies to your operation
Tick the boxes that apply to your operation.
Risk assessment is illustrative. Consult an agricultural waste adviser for NVZ-specific compliance planning. PHANTOM EcoTech site assessments: phantomecotech.com/contact.
Can Subcritical Water Hydrolysis Destroy Antibiotic Residues in Poultry Litter That Survive Conventional Composting?

Yes — and this is the single most important technical differentiator between subcritical water hydrolysis and every other on-site litter treatment option, including windrow composting, in-vessel composting, and anaerobic digestion.
- Conventional composting temperatures: 55–70°C at peak — insufficient to break the molecular structure of tetracyclines, sulfonamides, and fluoroquinolones, which are the three antibiotic classes most commonly detected in UK broiler litter
- Subcritical water hydrolysis operating conditions: 180–220°C at 2–4 MPa pressure — conditions that break the carbon-nitrogen bonds in antibiotic molecules through thermochemical cleavage, not biological degradation
- Published reduction rates for tetracycline in subcritical water at 200°C: >99.7% destruction within a 30-minute cycle, compared to less than 70% reduction after 60 days of windrow composting at optimal temperature
- Regulatory trajectory: the EA's current guidance on spreading composted poultry litter does not require antibiotic testing — but the Sustainable Farming Incentive and the NFU's AMR commitments are moving toward mandatory testing before land application, which composted litter will fail
This applies to operations where litter comes from high-antibiotic-use production units and where the output fertiliser is intended for land application or resale — it does NOT apply if the litter output is being used solely as fuel or industrial feedstock where antibiotic residues are destroyed by incineration anyway.
Scenario: A poultry farm supplying litter compost to a local organic vegetable grower is asked to provide antibiotic residue data before the next delivery. Their conventional compost operation cannot supply this data — and the grower terminates the supply agreement. The farm's £18,000 annual compost revenue disappears overnight.
For the full nitrogen recovery comparison across livestock waste streams, see Turn Livestock Manure into Organic Fertilizer.
What Does On-Site Subcritical Water Hydrolysis Actually Cost Per Tonne for a Poultry Litter Volume?
On-site subcritical water hydrolysis costs approximately £8–£14 per tonne to operate — and in most scenarios the liquid fertiliser output value of £25–£45 per tonne means the net cost per tonne processed is negative. Payback on capital is typically 18–28 months for operations generating 600+ tonnes of off-farm litter per year, based on the combined disposal saving and fertiliser revenue. The calculation changes completely once the fertiliser revenue side of the ledger is counted — which most initial cost-per-tonne comparisons omit entirely.
In practice, working with farm business advisors on capital investment appraisals for the 500-to-5,000 tonne per year litter range, the question that stops the conversation is never "does this work" — it's "what's the payback period when I net the disposal saving against the capital cost?"
- Operating cost (kerosene boiler fuel, maintenance, consumables): approximately £8–£14 per tonne processed, depending on litter moisture content and cycle throughput
- Output value — liquid fertiliser concentrate at 1:500 dilution: estimated £25–£45 per tonne of litter processed, based on avoided synthetic nitrogen cost at current urea pricing and a conservative 60% NPK recovery rate
- Net cost per tonne when output value is credited: negative in most scenarios — meaning the unit generates a positive margin per tonne rather than a disposal cost
- Payback period on capital: typically 18–28 months for operations generating 600+ tonnes of off-farm litter per year, based on the combined disposal saving and fertiliser revenue
This applies when the litter output is high enough to justify a dedicated on-site unit and where the processed liquid fertiliser can be applied on-farm or sold locally — it does NOT apply for operations generating under 300 tonnes per year of haul-off litter, where the capital cost per tonne processed does not reach break-even within a reasonable payback window.
Scenario: A 200,000-bird broiler estate generating 1,600 tonnes per year, hauling 800 tonnes off-farm at £35/tonne. Current haulage cost: £28,000/year. Synthetic nitrogen replacement cost: £20,000/year. Total disposal burden: £48,000/year. After installing on-site SWH: operating cost £9,600/year, fertiliser revenue £28,800/year. Net annual improvement: £67,200. Payback on a PHANTOM unit at capital cost: under 22 months.




Why Is Poultry Litter Still Being Hauled Off-Farm When It Contains £25–£45/Tonne of Recoverable Fertiliser Value?
If you've read this far, you understand the cost structure clearly: you're paying to dispose of something you then repurchase in synthetic form. That's not a haulage problem. It's a processing gap.
The reason this gap has persisted is structural. Conventional composting is slow and cannot destroy antibiotic residues. AD facilities reject high-ammonia litter or impose gate fees that eliminate the economics. And until recently, no compact on-site system existed that could sterilise, deodorise, and convert solid poultry litter into a dilutable liquid fertiliser in under an hour without specialist operators or significant infrastructure.
That's exactly what PHANTOM's subcritical water hydrolysis process eliminates. By processing litter at 180–220°C under pressure, the system destroys pathogens at a 6-log reduction rate, breaks down antibiotic residues that survive composting, and produces an amino acid-rich liquid concentrate that applies at 1:500 dilution — staying below NVZ nitrogen loading thresholds on spreading application. The disposal invoice disappears. The synthetic nitrogen purchase is replaced. And the ammonia problem that triggers AD rejection is neutralised in the vessel, not managed around it.
Calculate your poultry farm's waste treatment ROI against your specific litter tonnage, haulage rate, and nitrogen replacement spend at phantomecotech.com/waste-treatment-machine.
Poultry Litter ROI Calculator
What Is Your Litter Disposal Actually Costing You?
▸ Adjust SWH assumptions
Assumes 8 kg litter/bird/year (broiler). SWH operating cost ~£11/t at rated throughput (£33/3t cycle). Fertiliser revenue based on 60% NPK recovery at current urea pricing. Capital cost is illustrative — actual cost depends on configuration and site. Figures are for illustration only — request a site-specific assessment at phantomecotech.com/contact.
For UK broiler and layer operations in NVZ areas, the true all-in cost is typically £55–£85 per tonne — combining haulage (£20–£40/t), NVZ compliance overhead (£5–£12/t), synthetic nitrogen replacement (£18–£35/t), and any AD gate surcharges (£0–£15/t). Most farm accounts only record the haulage invoice, systematically under-counting the real disposal burden.
AD facilities reject high-ammonia poultry litter because broiler litter frequently contains 6–12 g/L ammonia-nitrogen — well above the 3–5 g/L threshold that inhibits methanogenic bacteria. Outright rejection rates for first-time enquiries are estimated at 30–40%. Where the facility accepts the load, gate surcharges of £8–£15/tonne are typical.
Yes. At 180–220°C under 2–4 MPa pressure, subcritical water hydrolysis achieves greater than 99.7% destruction of tetracyclines, sulfonamides, and fluoroquinolones within 30 minutes. Conventional composting at 55–70°C cannot break the molecular structure of these compounds — a growing risk as retailers and organic buyers increase residue testing requirements.
Typically 18–28 months for operations generating 600+ tonnes of off-farm litter per year. The calculation combines disposal saving (avoided haulage + nitrogen replacement) with fertiliser revenue from the liquid concentrate output. A 200,000-bird broiler estate typically achieves annual improvement of £65,000–£70,000.
The Nitrates (England) Regulations 2015 set a 170 kg N/ha limit for total nitrogen from organic sources in NVZ areas. Broiler litter contains 28–38 kg N/tonne dry weight — meaning the limit equates to only 4.5–6 tonnes of litter per hectare per year. Underestimating poultry litter nitrogen content is one of the most common EA compliance triggers.
⚠️ Disclaimer: The information in this article is for general informational purposes only and does not constitute legal, regulatory, financial, or agricultural advice. Cost figures, disposal rates, and payback estimates are illustrative and based on publicly available UK industry data and PHANTOM EcoTech internal modelling. Actual results depend on waste composition, haulage distances, NVZ designation, output revenue, and site conditions. Always seek independent professional advice before making capital investment decisions. ~1.27 USD/GBP conversion rate at time of publication.